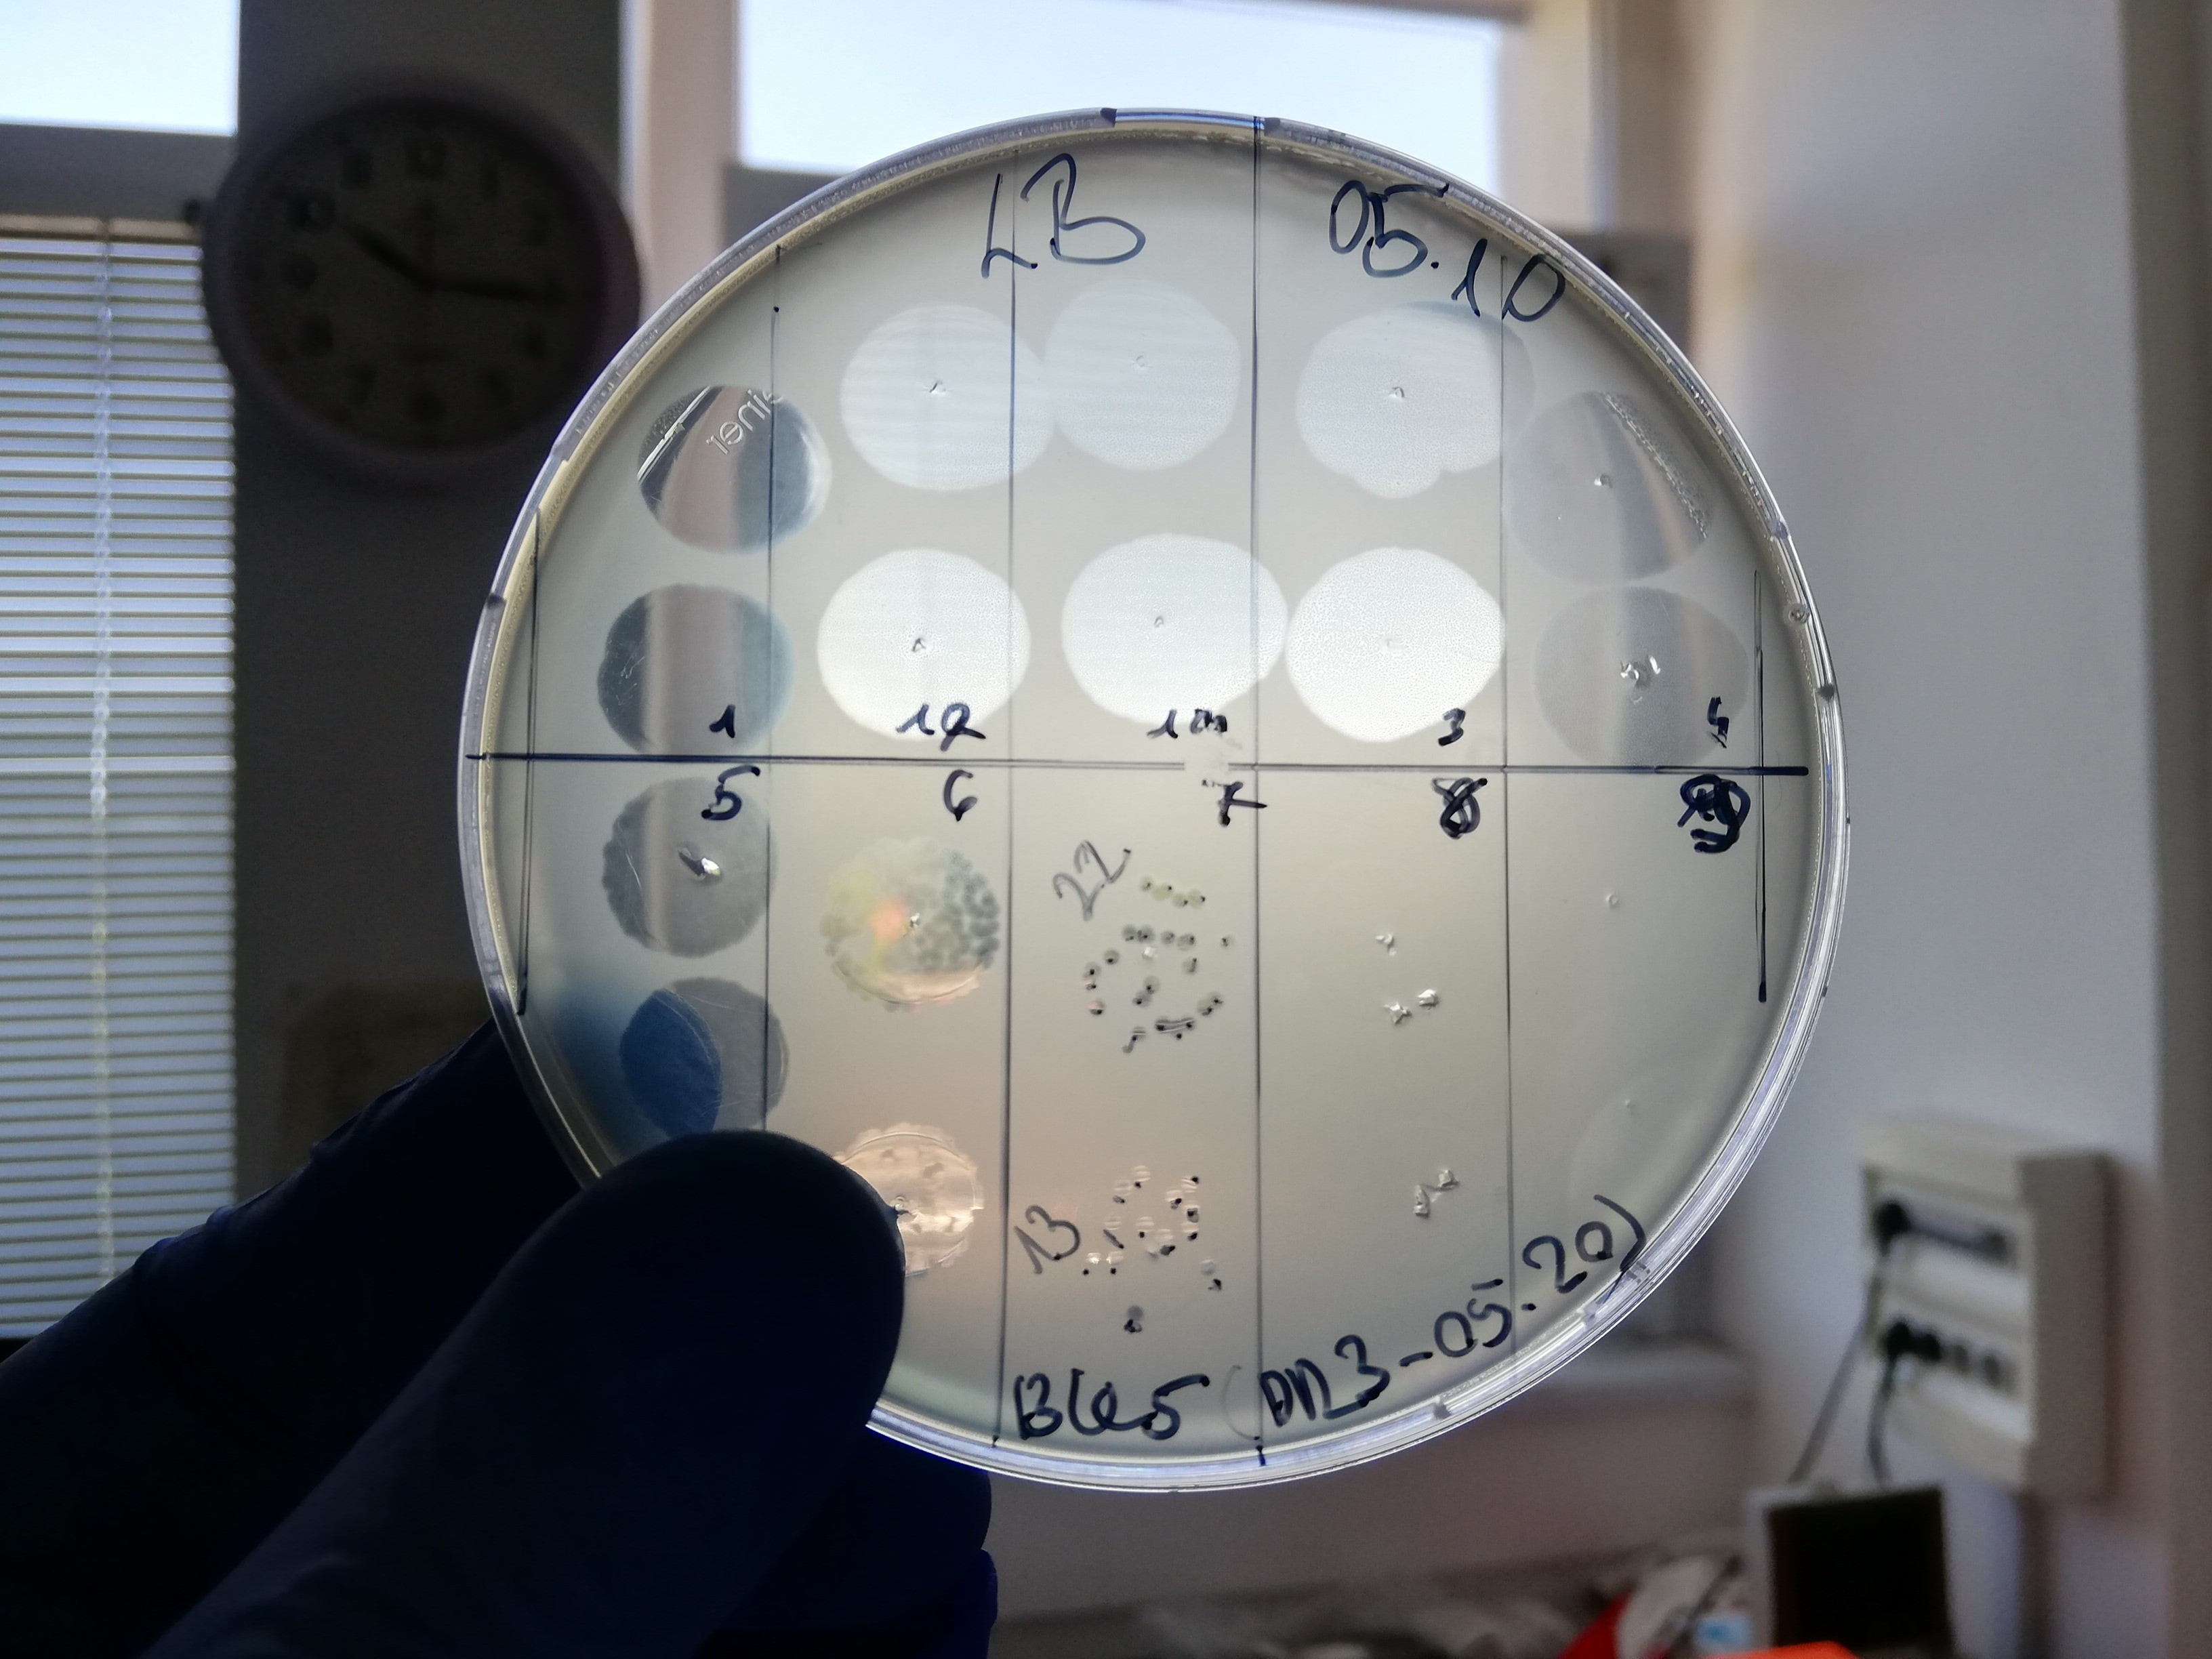

As bacteria become resistant to antibiotics, bacteriophage therapy offers a promising alternative.
However, the process of developing customised bacteriophage treatments for specific bacterial strains is often slow and resource-intensive, which can delay critical treatments. At BRC Bio Ltd., a spin-off from the HUN-REN Biological Research Centre in Szeged, we are developing a groundbreaking technology that accelerates access to targeted bacteriophage therapies.
Focused on hospital-acquired infections caused by highly resistant pathogens like Acinetobacter baumannii and Klebsiella pneumonia, our project aims to deliver rapid, effective solutions to counter these high-priority threats.
Over this project, we are establishing the GMP-compliant production of specialised bacteriophage preparations for healthcare institutions across Europe.
Expanding our “Phage Bank” and setting the foundation for commercial access, we aim to make personalised bacteriophage therapy an integral part of fighting antibiotic-resistant infections. Our team of experts, with over a decade of experience in antibiotic resistance, is committed to leading this essential innovation.